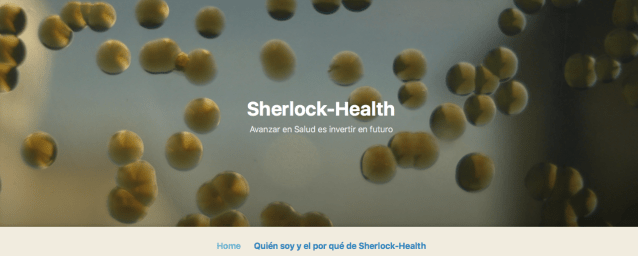
Captura de pantalla 2018-10-17 a las 10.51.39.png

La divulgación científica está de enhorabuena. Uno de los mejores profesores, investigadores y comunicadores de la Universidad de Murcia acaba de dar el paso adelante que todos esperábamos y ha abierto un blog. Se trata de Christian de la Fe, compañero de la Facultad de Veterinaria…y de otras aventuras universitarias.

Christian de la Fe en plena acción.
¿Y este blog qué temática aborda? En este enlace el propio Christian os lo cuenta pero ya les adelanto que este gran valor de la Universidad de Murcia es, a la tempranísima edad de 41 años, Catedrático de Sanidad Animal…un área prácticamente virgen en el campo de la divulgación científica. Por ello considero que este nuevo blog es más que necesario. ¿Y cómo se llama el blog? Pues mi gran amigo Christian ha elegido un nombre que me parece, permítanme la expresión, cojonudo: “Sherlock-health”.
Pero Christian, alguien con el que me identifico muchísimo personal y profesionalmente, no ha querido dejar pasar más tiempo antes de publicar su primer post. Aquí lo tienen. Se trata de “La enfermedad del Nilo oeste está….. al oeste del Nilo.” . Léanla detenidamente, no tiene desperdicio.
No se vayan todavía que aun hay más. Como dicen en mi pueblo “Si hay que ir se va…pero ir pa ná es tontería”. Por eso Christian también ha abierto una cuenta de twitter que recomiendo encarecidamente seguir. Se trata de @health_sherlock .

Antes de acabar quiero agradecer a Christian de la Fe, un comunicador inigualable y que está profundamente identificado con la divulgación científica, que haya sacado tiempo de su apretadísima agenda docente e investigadora para divulgar la ciencia que hay detrás de su área de conocimiento a la sociedad. A partir de hoy si quieren leer con rigor acerca de la Sanidad animal (y también humana) ya tienen un sitio especial donde hacerlo…. En “Sherlock-health”.
Jose


Qué buena noticia! Estaremos muy atentos a su contenido 🙂
Pingback: Atención: nace “Sherlock Health”…un nuevo blog de divulgación científica — SCIENTIA | Platino Ulloa
¡Una noticia genial! Me parece fenomenal que compartas los blogs de tus amigos investigadores y sobre todo por el contenido de ellos. Te lo agradezco mucho.
Pingback: Lo más destacado del Día Europeo del Uso Prudente de antibióticos - Avicultura